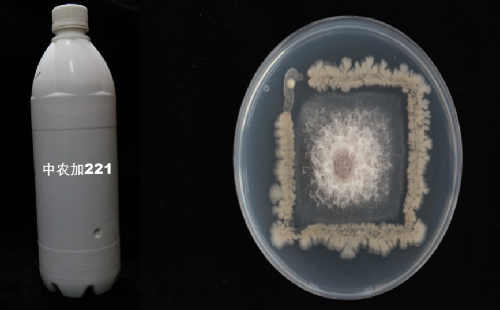

中农加221菌剂
来源:中国农业科学院农产品加工研究所
发布时间:2019-10-14 09:02
点击:18
中农加221菌剂,以自然发病的玉米田中分离的多种拮抗微生物为原料,采用独特发酵工艺生产。通过定量复合技术保证了各个菌株的纯正性,产品质量稳定,有效活菌数高达2000亿/毫升,活性物质产量丰富。可在玉米种植过程中用于防控玉米茎穗腐病等多种病害、降低呕吐毒素、伏马菌素、黄曲霉毒素等多种真菌毒素的污染风险,保障玉米的绿色安全生产。
该产品已实现中试规模生产,目前已经申请国家发明专利2项。
技术团队:农产品真菌毒素防控创新团队,本产品由创新团队骨干成员郭维研究员开发。